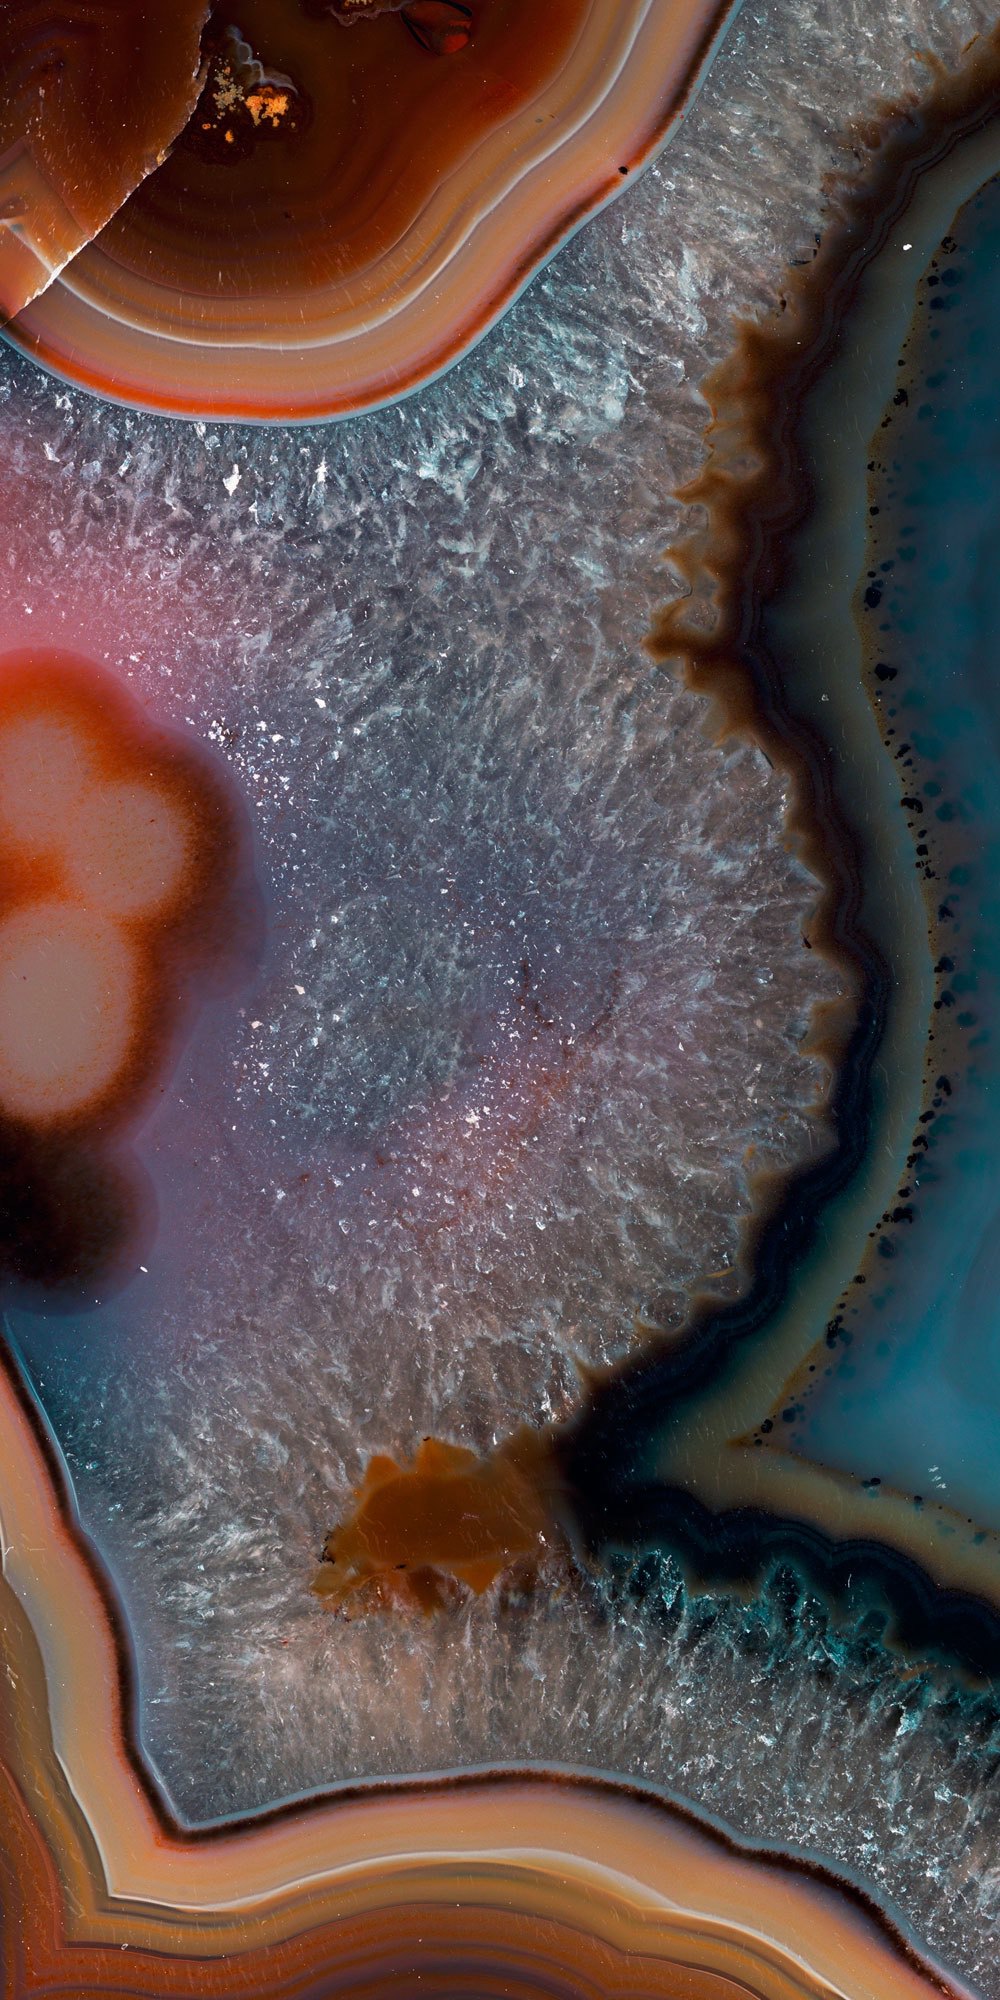
PANELI - Dezen

PANELI
TECNOGRAFICA

TECNOGRAFICA
TECNOGRAFICA DECORATIVE PANELS - Dekorativni paneli predstavljaju novu i inovativnu realnost u svetu zidnih murala!
Karakterističnost ovih proizvoda je to što mogu da se modifikuju i prilagode vašem zidu!
Paneli su velikog formata, do 150x300cm i sa optimalnom debljinom koja im daje elegantan izgled.
Tecnografica paneli su...
PANELI
TECNOGRAFICA DECORATIVE PANELS - Dekorativni paneli predstavljaju novu i inovativnu realnost u svetu zidnih murala!
Karakterističnost ovih proizvoda je to što mogu da se modifikuju i prilagode vašem zidu!
Paneli su velikog formata, do 150x300cm i sa optimalnom debljinom koja im daje elegantan izgled.
Tecnografica paneli su uradjeni od high-tech materijala a otpornost na temperaturu se kreće od -20° C do 40° C. Veoma su savitljivi, u izboru od 2mm do 23mm debljine.
Možete izabrati 5 različitih varijanti panela čija je završna obrada dovedena do perfekcije:
- Smart Panel Glossy – Dizajn simulira prirodno i drago kamenje kao što je oniks, ahat, kvarc, mermer i granit. Proizvedeni od polikarbonata u dimenziji do 150x300mm, ultra- tanak (samo 2.5mm), ultra-lagan (do 3kg/m2), i veoma fleksibilan. Iz tog razloga je prilagodljiv i za zaobljene zidove i površine!
- Smart Panel Matt – Ovaj mat panel je prikladan za reprodukciju grubih površina sa efektom betona, kamena, metala i čelika.
- Dècora LED - Panel sa integrisanim svetlosnim sistemom koji kombinuje LED tehnologiju. Može da se upravlja i programira putem daljinskog upravljanja i aplikacije. Potrošnja energije - A klasa.
DÈCORA GLASS BACKLIT - Dekorativna staklena ploča od laminiranog stakla dostupna je iu verziji sa pozadinskim osvetljenjem, integrisana sa LED sistemom osvetljenja. Ukupna debljina Decora stakla pozadinskog osvetljenja je 23,7 mm. Svetleća panelna struktura, prema patentu Tecnografice, omogućava ravnomernu distribuciju svetlosti po celoj površini ploče. Pogodni su za velike projekte koji zahtevaju prefinjen i spektakularan dekorativni efekat, posebno u Horeca, komercijalnoj i stambenoj industriji.
- Dècora Glass – Eksluzivni dekorativni panel od laminiranog stakla. Zahvaljujući velikim dimenzijama, do 1480x3000mm, i debljinom od samo 8.7 mm, ovi paneli su pogodni za pokrivanje velikih površina! Otpornost stakla omogućava upotrebu ovih panela u vidu radne ploče ili pulta.
Sve Smart Panel varijante panela se mogu koristiti u vlažnim okruženjima, poput kupatila i Spa centara, zbog njihovog polikarbonatnog sastava.
Ukoliko su Vam potrebne fotografije u visokim rezolucijama možete ih pronaći na sajtu Tecnografica Italian Wallcoverings.
Karakterističnost ovih proizvoda je to što mogu da se modifikuju i prilagode vašem zidu!
Paneli su velikog formata, do 150x300cm i sa optimalnom debljinom koja im daje elegantan izgled.
Tecnografica paneli su...
PANELI
TECNOGRAFICA DECORATIVE PANELS - Dekorativni paneli predstavljaju novu i inovativnu realnost u svetu zidnih murala!
Karakterističnost ovih proizvoda je to što mogu da se modifikuju i prilagode vašem zidu!
Paneli su velikog formata, do 150x300cm i sa optimalnom debljinom koja im daje elegantan izgled.
Tecnografica paneli su uradjeni od high-tech materijala a otpornost na temperaturu se kreće od -20° C do 40° C. Veoma su savitljivi, u izboru od 2mm do 23mm debljine.
Možete izabrati 5 različitih varijanti panela čija je završna obrada dovedena do perfekcije:
- Smart Panel Glossy – Dizajn simulira prirodno i drago kamenje kao što je oniks, ahat, kvarc, mermer i granit. Proizvedeni od polikarbonata u dimenziji do 150x300mm, ultra- tanak (samo 2.5mm), ultra-lagan (do 3kg/m2), i veoma fleksibilan. Iz tog razloga je prilagodljiv i za zaobljene zidove i površine!
- Smart Panel Matt – Ovaj mat panel je prikladan za reprodukciju grubih površina sa efektom betona, kamena, metala i čelika.
- Dècora LED - Panel sa integrisanim svetlosnim sistemom koji kombinuje LED tehnologiju. Može da se upravlja i programira putem daljinskog upravljanja i aplikacije. Potrošnja energije - A klasa.
DÈCORA GLASS BACKLIT - Dekorativna staklena ploča od laminiranog stakla dostupna je iu verziji sa pozadinskim osvetljenjem, integrisana sa LED sistemom osvetljenja. Ukupna debljina Decora stakla pozadinskog osvetljenja je 23,7 mm. Svetleća panelna struktura, prema patentu Tecnografice, omogućava ravnomernu distribuciju svetlosti po celoj površini ploče. Pogodni su za velike projekte koji zahtevaju prefinjen i spektakularan dekorativni efekat, posebno u Horeca, komercijalnoj i stambenoj industriji.
- Dècora Glass – Eksluzivni dekorativni panel od laminiranog stakla. Zahvaljujući velikim dimenzijama, do 1480x3000mm, i debljinom od samo 8.7 mm, ovi paneli su pogodni za pokrivanje velikih površina! Otpornost stakla omogućava upotrebu ovih panela u vidu radne ploče ili pulta.
Sve Smart Panel varijante panela se mogu koristiti u vlažnim okruženjima, poput kupatila i Spa centara, zbog njihovog polikarbonatnog sastava.
Ukoliko su Vam potrebne fotografije u visokim rezolucijama možete ih pronaći na sajtu Tecnografica Italian Wallcoverings.

TAPETE
PANELI
Paneli po merama vašeg zida. High-tech materijali, savitljivost, LED tehnologija, lako instaliranje. Moderan dizajn i kvalitet.

Scroll za zoom • Klik za povećanje • Prevuci za pomeranje • ←→ za navigaciju
more about ...
Wall
solutions




























